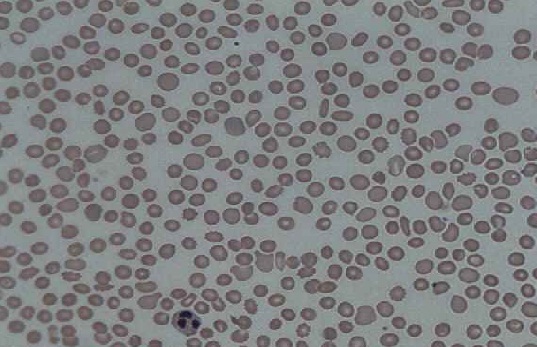

¿Qué es la trombocitopoyesis?
La trombocitopoyesis (también trombopoyesis) es el proceso de formación y liberación de las plaquetas. Este proceso se lleva a cabo en la médula ósea, al igual que la eritropoyesis y la granulopoyesis. La formación de las plaquetas comprende dos fases: la megacariopoyesis y la trombocitopoyesis. La megacariopoyesis se inicia a partir de la célula precursora del linaje mieloide hasta la formación del megacariocito maduro.
Por otro lado, la trombocitopoyesis comprende una serie de eventos por los que pasa el megacariocito. Esta célula va recibiendo distintas señales, dependiendo del sitio en el cual se encuentre.
Mientras la célula esté dentro del estroma osteoblástico estará inhibida, pero al salir al espacio extracelular del compartimiento vascular es activada por la presencia de sustancias estimulantes.
Estas sustancias son el factor von Willebrand, el fibrinógeno y el factor de crecimiento endotelial vascular. Una vez activadas, las prolongaciones citoplasmáticas del megacariocito, denominadas proplaquetas, se fragmentarán para dar origen a las proplaquetas y a las plaquetas.
Gracias al proceso de regulación de la trombocitopoyesis es posible mantener la homeostasis en cuanto al número circulante de plaquetas. Como factores estimulantes de la trombocitopoyesis existen la trombopoyetina, la interleuquina 3 (IL3), IL 6, y la IL 11. Y como factores inhibitorios, están el factor plaquetario 4 y el factor de crecimiento transformante (TGF) β.
Existen diversas enfermedades donde el número de plaquetas circulantes está alterado, así como su morfología o su función. Estas anormalidades crean graves problemas en el individuo que las padece, especialmente hemorragias y trombosis, entre otras complicaciones.
Proceso de la trombocitopoyesis
La formación de las plaquetas se puede dividir en dos procesos, el primero se denomina megacariocitopoyesis y el segundo, trombocitopoyesis.
Como se sabe, todos los linajes celulares provienen de la célula madre pluripotencial. Esta célula se diferencia en dos tipos de células progenitoras, una del linaje mieloide y la otra del linaje linfoide.
De la célula progenitora del linaje mieloide surgen 2 tipos de células, una progenitora megacariocítica-eritroide y una progenitora granulocítica-macrófago.
De la célula progenitora megacariocítica-eritroide se forman los megacariocitos y los eritrocitos.
Megacariocitopoyesis
La megacariocitopoyesis comprende el proceso de diferenciación y maduración de las células desde la burst-forming unit (BFU-Meg) hasta la formación del megacariocito.
CUF-GEMM
Esta célula surge de la célula madre y de ella derivan las células progenitoras de los linajes celulares granulocítica-macrófagos y megacariocítica-eritroide.
BFU-Meg
Esta célula es el ejemplar más primitivo de la serie megacariocítica. Tiene gran capacidad proliferativa. Se caracteriza por presentar en su membrana el receptor CD34+/HLADR-
CFU-Meg
Su capacidad proliferativa es menor a la anterior. Está un poco más diferenciada que la anterior y en su membrana presenta el receptor CD34+/HLADR+.
Promegacarioblasto
Mide de 25 y 50 µm, presenta un núcleo de forma irregular y de gran tamaño. El citoplasma es ligeramente basófilo y puede tener ligera policromasia. Puede tener de 0 a 2 nucleólos.
Megacarioblasto
Esta célula se caracteriza por tener un tamaño más pequeño que el megacariocito (15-30 µm), pero mucho más grande que otras células. Por lo general, posee un núcleo visible bilobulado, aunque en ocasiones puede existir sin lobulaciones.
La cromatina es laxa y se pueden apreciar varios nucléolos. El citoplasma es basófilo y escaso.
Promegacariocito
Esta célula se caracteriza por presentar núcleo polilobulado y escotado. El citoplasma es más abundante y se distingue por ser policromático.
Megacariocito
Es la célula de mayor tamaño, mide entre 40-60 µm, aunque se han visto megacariocitos que miden 100 µm. Los megacariocitos presentan abundante citoplasma, que suele ser eosinófilo. Su núcleo es poliploide, de gran tamaño y presenta varias lobulaciones.
En el proceso de maduración de esta célula va adquiriendo características propias del linaje, como la aparición de gránulos plaquetarios específicos (azurófilos), o la síntesis de ciertos componentes del citoesqueleto, como actina, tubulina, filamina, alfa-1 actinina y miosina.
También presenta la invaginación de la membrana de la célula que va formando un sistema complejo de demarcación de membrana que se extenderá por todo el citoplasma. Esta última es muy importante, pues es la base de la formación de las membranas plaquetarias.
Otras características de estas células son las siguientes:
- Aparición de marcadores específicos en su membrana, tales como: glicoproteína IIbIIIa, CD 41 y CD 61 (receptores de fibrinógeno), complejo glicoproteico Ib/V/IX, CD 42 (receptor del factor von Willebrand).
- Endomitosis: proceso en el que la célula multiplica su ADN al doble sin necesidad de dividirse, a través de un proceso denominado mitosis abortiva. Este proceso se repite en varios ciclos. Esto le da la propiedad de ser una célula grande que producirá muchísimas plaquetas.
- Aparición de prolongaciones citoplasmáticas similares a pseudópodos.
Plaquetas
Son estructuras muy pequeñas, miden entre 2-3 µm, no tienen núcleo y presentan 2 tipos de gránulos denominados alfa y densos. De todas las células mencionadas, estas son las únicas que pueden verse en los frotis de sangre periférica. Su valor normal oscila entre 150.000 a 400.000 mm3. Su vida media es de 8-11 días, aproximadamente.
Trombocitopoyesis
El megacariocito ya maduro será el responsable de formar y liberar las plaquetas. Los megacariocitos, al estar cerca del endotelio vascular en los sinusoides de la médula ósea, forman alargamientos de su citoplasma, creando una especie de tentáculos o pseudópodos que reciben el nombre de proplaquetas.
La zona más externa de las proplaquetas se fragmenta para dar origen a las plaquetas. La liberación plaquetaria se da en los vasos sanguíneos, y es ayudada por la fuerza del torrente circulatorio. Para ello, la proplaqueta debe atravesar la pared endotelial.
Algunos autores aseguran que existe una fase intermediaria entre la proplaqueta y las plaquetas, que han denominado preplaquetas. Esta transformación de proplaqueta a preplaqueta parece ser un proceso reversible.
Las preplaquetas son más grandes que las plaquetas y tienen forma discoide. Finalmente se convierten en plaquetas. Al cabo de pocas horas, de un megacariocito habrán surgido un total aproximado de 1.000 a 5.000 plaquetas.
Estimulantes de la trombocitopoyesis
Entre las sustancias estimuladoras están el factor estimulador de la célula madre, la interleuquina 3, la interleuquina 6, la interleuquina 11 y la trombopoyetina.
- Interleuquina 3. Esta citoquina interviene aumentando la vida útil de las células madre más primitivas e inmaduras del linaje megacariocítico. Esto lo hace a través de la inhibición del proceso de apoptosis, o muerte celular programada de estas células.
- Interleuquina 6. Es una interleuquina pro-inflamatoria que presenta diversas funciones en el organismo. Una de sus funciones es estimular la síntesis de precursores hematopoyéticos, entre los que se encuentra la estimulación de los precursores del linaje megacariocítico. Actúa desde la diferenciación de la CFU-GEMM hasta la CFU-meg.
- Interlequina 11. Al igual que la trombopoyetina, actúa a nivel de todo el proceso de la megacariocitopoyesis, es decir, desde la estimulación de la célula pluripotencial hasta la formación del megacariocito.
- Trombopoyetina. Esta importante hormona se sintetiza principalmente en el hígado y secundariamente en el riñón y en el estroma de la médula ósea. La trombopoyetina actúa en la médula ósea, estimulando la formación de megacariocitos y plaquetas. Esta citoquina interviene en todas las fases de la megacariopoyesis y trombocitopoyesis. Se cree que también estimula el desarrollo de todas las líneas celulares. Además contribuye al buen funcionamiento de las plaquetas.
Regulación de la trombocitopoyesis
Como todo proceso, la trombocitopoyesis es regulada a través de ciertos estímulos. Algunos favorecen la formación y liberación de las plaquetas a la circulación y otros inhiben el proceso. Estas sustancias son sintetizadas por células del sistema inmunitario, por el estroma de la médula ósea y por células del sistema retículo endotelial.
El mecanismo de regulación hace que el número de plaquetas se mantenga a niveles normales en la circulación. Aproximadamente la producción de plaquetas a diario es de 1011.
El microambiente estromal de la médula ósea juega un papel fundamental en la regulación de la trombocitopoyesis.
A medida que se madura el megacariocito, este se va desplazando, pasando de un compartimiento a otro, es decir, pasa del compartimiento osteoblástico al vascular, siguiendo un gradiente quimiotáctico denominado factor derivado del estroma -1.
Mientras el megacariocito esté en contacto con componentes del compartimiento osteoblástico (colágeno tipo I), la formación de las proplaquetas estará inhibida.
Esta solo se activará cuando entre en contacto con el factor von Willebrand y el fibrinógeno presente en la matriz extracelular del compartimiento vascular, junto a factores de crecimiento, como por ejemplo, el factor de crecimiento endotelial vascular (VEGF).
- Trombopoyetina. Es eliminada por las plaquetas cuando es captada a través de su receptor MPL. Es por ello que cuando las plaquetas aumentan la trombopoyetina disminuye, debido a la alta depuración. Pero cuando bajan las plaquetas el valor plasmático de la citoquina sube y estimula la médula para la formación y liberación de las plaquetas. La trombopoyetina sintetizada en la médula ósea es estimulada por la disminución del número de plaquetas en la sangre, pero la formación de la trombopoyetina en el hígado solo se estimula cuando el receptor Ashwell-Morell del hepatocito se activa en presencia de plaquetas desialinizadas. Las plaquetas desialinizadas provienen del proceso de apoptosis que sufren las plaquetas cuando envejecen, siendo captadas y removidas por el sistema monocito-macrófago a nivel del bazo.
- Factores inhibidores. Dentro de las sustancias que frenan el proceso de formación plaquetaria están el factor plaquetario 4 y el factor de crecimiento transformante (TGF) β.
- Factor plaquetario 4. Esta citoquina está contenida en los gránulos alfa de las plaquetas. También sa le conoce como factor de crecimiento de los fibroblastos. Es liberada durante la agregación plaquetaria y frena la megacariopoyesis.
- Factor de crecimiento transformante (TGF) β. Es sintetizada por diversos tipos de células, como macrófagos, células dendríticas, plaquetas, fibroblastos, linfocitos, condrocitos y astrocitos, entre otras. Su función está relacionada con la diferenciación, proliferación y activación de diversas células y además participa en la inhibición de la megacariocitopoyesis.
Enfermedades producidas por desequilibrio en la trombocitopoyesis
Existen muchos trastornos que pueden alterar la homeostasis en relación con la formación y destrucción plaquetaria. A continuación se mencionan algunos de ellos.
- Trombocitopenia amegacariocítica congénita. Es una extraña patología hereditaria que se caracteriza por una mutación en el sistema trombopoyetina/receptor MPL (TPO/MPL). Por ello, en estos pacientes la formación de megacariocitos y plaquetas es casi nula y con el tiempo evolucionan a una aplasia medular, lo que pone de manifiesto que la trombopoyetina es importante para la formación de todas las líneas celulares.
- Trombocitemia esencial. Es una patología poco frecuente en la que se produce un desequilibrio en la trombocitopoyesis, lo que origina un aumento exagerado del número de plaquetas de manera constante en sangre y una producción hiperplásica de los precursores plaquetarios (megacariocitos) en la médula ósea. Esta situación puede ocasionar trombosis o hemorragias en el paciente. El defecto se produce a nivel de la célula madre, la cual se inclina hacia la producción exagerada de un linaje celular, en este caso, la megacariocítica.

- Trombocitopenia. Se denomina trombocitopenia al número reducido de plaquetas en la sangre. La trombocitopenia puede tener muchas causas, entre las que se pueden mencionar: retención de plaquetas en el bazo, infecciones bacterianas (E. coli enterohemorrágica) o infecciones virales (dengue, mononucleosis). También aparecen por enfermedades autoinmunes, como lupus eritematoso sistémico, o de origen medicamentoso (tratamientos con sulfamidas, heparina, anticonvulsivos). Otras causas probables son la disminución de la producción plaquetaria o un aumento en la destrucción de las plaquetas.
- Síndrome de Bernard-Soulier. Es una enfermedad congénita hereditaria poco frecuente. Se caracteriza por presentar plaquetas de morfología y función anormal provocada por una alteración genética (mutación), donde el receptor del factor von Willebrand (GPIb/IX) está ausente. Por tanto, los tiempos de coagulación están aumentados, hay trombocitopenia y presencia de macroplaquetas circulantes.
- Púrpura trombocitopénica inmunológica. Esta condición patológica se caracteriza por la formación de auto-anticuerpos contra las plaquetas, causando su destrucción temprana. En consecuencia, hay una disminución importante del número de plaquetas circulantes y una baja producción de ellas.
Referencias
- Heller, P. Megacariocitopoyesis y trombocitopoyesis. Fisiología de la hemostasia normal. Recuperado de sah.org.ar.
- Bermejo, E.. Plaquetas. Fisiología de la hemostasia normal. Recuperado de sah.org.ar.
- Trombopoyesis. Recuperado de es.wikipedia.org.
- Vidal, J. Trombocitemia esencial. Recuperado de osakidetza.euskadi.eus.